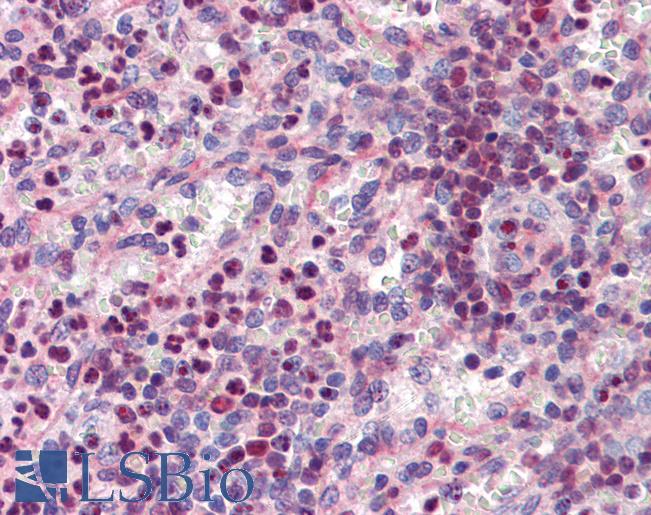

Formulation Supplied at 0.5 mg/ml in Tris saline, 0.02% sodium azide, pH7.3 with 0.5% bovine serum albumin.
| |
Unit Size 100 µg | |
Storage Instructions Aliquot and store at -20°C. Minimize freezing and thawing. | |
Synonym / Alias Names hematopoietic transcription factor PU.1|SPI-1 proto-oncogene|31 kDa transforming protein|SPI-A|SPI-1|SFPI1|hCG_25181|spleen focus forming virus (SFFV) proviral integration oncogene spi1|SPI1|PU.1 | |
Accession ID NP_001074016.1; NP_003111.2 | |
Blocking Peptide EBP08429 | |
Immunogen Peptide with sequence C-DLYQRQTHEYY, from the internal region of the protein sequence according to NP_001074016.1; NP_003111.2. | |
Product Comments This antibody is expected to recognise both reported isoforms (NP_001074016.1; NP_003111.2). | |
Peptide Sequence C-DLYQRQTHEYY | |
Purification Method Purified from goat serum by ammonium sulphate precipitation followed by antigen affinity chromatography using the immunizing peptide. | |
Shipping Instructions Refrigerated | |
Predicted Species Human, Rat | |
Reactive Species Human | |
Human Gene ID 6688 | |
Rat Gene ID 366126 | |
Product Grade ![]() | |
IHC Results Paraffin embedded Human Spleen and Colon (lymphoid aggregate). Recommended concentration: 3.75µg/ml. | |
ELISA Detection Limit Antibody detection limit dilution 1:32000. | |
Western Blot Approx 40kDa band observed in lysates of DAUDI and K562 (calculated MW of 31.2kDa according to NP_001074016.1 and of 31.1kDa according to NP_003111.2). The observed molecular weight corresponds to earlier findings in literature with different antibodies (Harendza S et al, J Biol Chem. 2000 Jun 30;275(26):19552-9.; PMID: 10867017). Recommended concentration: 0.03-0.1µg/ml. Primary incubation was 1 hour. | |
Application Type Pep-ELISA, WB, IHC |
Goat Anti-PU.1 Antibody
$431.00
| SKU | Unit Size | Price |
|---|---|---|
Select a unit size:
Documents |